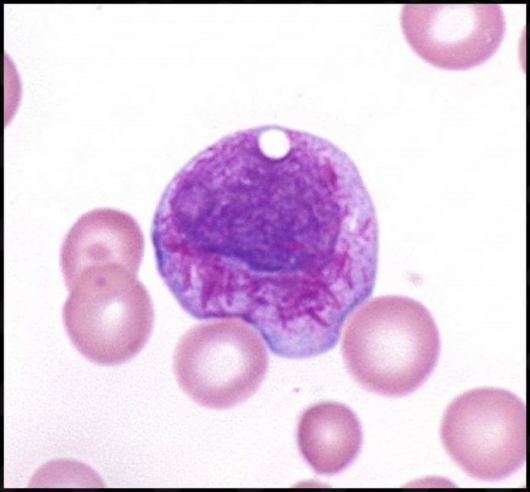
Noé Benjamín Vega Tapia-6

Dr.
Noé Benjamín Vega Tapia
Hematólogo
·
Ver más
sobre las especializaciones
Puerto Vallarta 1 dirección
No. de cédula: 10439846 7365990
25 opinionesExperiencia
Enfocado en:
- Hemopatías
- Transfusión y banco de sangre
- Trombosis y hemostasia
- Inmuno-oncología
Principales enfermedades tratadas
- Anemia ferropénica
- Linfoma no Hodgkin
- Linfoma de Hodgkin
- Anemia aplásica adquirida
- Mieloma múltiple
- +5 a11y_sr_more_diseases
Pacientes que atiendo
Tipos de consulta
Fotos y videos
Servicios y precios
-
Primera visita Hematología
-
-
Visitas sucesivas Hematología
-
-
Aspirado de médula ósea
-
-
Biometría
-
-
Biometría Hemática
-
-
-
-
-
-
-
-
-
-
-
Consultorio
Av. Francisco Villa 1389 C, Fluvial Vallarta , Puerto Vallarta 48312
Disponibilidad
Este especialista no ofrece reserva online en esta dirección
Número de teléfono
No se aceptan aseguradoras
Este especialista sólo acepta pacientes privados. Puede pagar directamente la cita para reservar, o encontrar otro especialista que acepte su aseguradora.
Opiniones
25 opiniones
-
I
I. A.C
Persona con calidad humana, se expresa de forma tal que al paciente le queda muy clara la opinión médica y sus observaciones bastante buenas .
• Consultorio privado • Primera visita Hematología •
-
L
Leticia Solorzano
Excelente, atención muy claro con la explicación y el tratamiento respetuoso y muy atento súper profesional
• Consultorio privado • Visitas sucesivas Hematología •
-
Paciente
El Dr. me transmitió confianza, sobretodo considerando que fue mi primera cita.
• Consultorio privado • Primera visita Hematología •
-
Y
Yuri
Buena atencion desde que te ingresan al consultorio, las insatlciones perfectas pero sobre todo la tencion y revision medica fue muy agradable y bien hecha
• Consultorio privado • Primera visita Hematología •
-
M
Martha Araceli
Esta aplicación podría funcionar si el médico o la asistente la atendieran. Ya que la cita se agendo en la app pero el médico ni enterado estaba.
• Consultorio privado • Primera visita Hematología •
-
A
Alma R.Aaguirre P
MUY AMABLE, MUY HUMANO Y MUY PROFESIONAL. GRS , aclaro todas mis dudas y ya salí más trankila
. Super recomendado.• Consultorio privado • Primera visita Hematología •
-
J
Javier Maciel
Excelente atención de especialista. explica muy bien a detalle y te resuelve cualquier duda que tengas ,da mucha confianza su persona para preguntar cualquier duda.
• Consultorio privado • Visitas sucesivas Hematología •
-
E
Esperanza CR
Excelente explica muy bien a detalle y te resuelve cualquier duda que tengas y es muy empático y da mucha confianza su persona para preguntar cualquier duda.
• Consultorio privado • Primera visita Hematología •
-
E
Ernesto gispert
Excelente atención del especialista, me explico perfectamente y con toda la paciencia del mundo lo que le cuestione, me canalizo con otro especialista
• Consultorio privado • Primera visita Hematología •
-
M
Mark Argo, DDS - US dentist retired
Dr. Vega was knowledgeable which made me feel very comfortable & confident. Excellent English (y espanol)! Highly recommend to have trust in him.
• Consultorio privado • Primera visita Hematología •